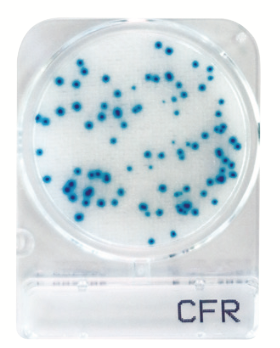
Compact Dry CFR 1400pc
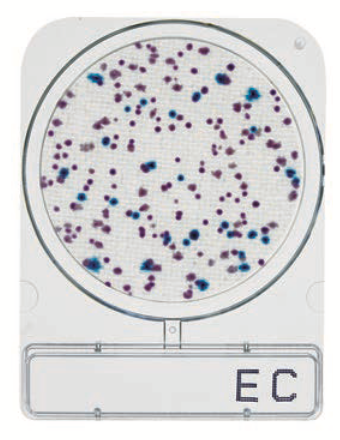
Compact Dry CC 240pc
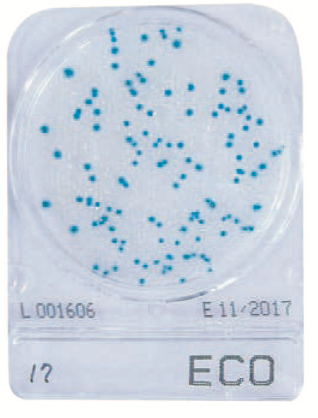
微生物快速测试片—大肠埃希氏菌，CompactDry ECO
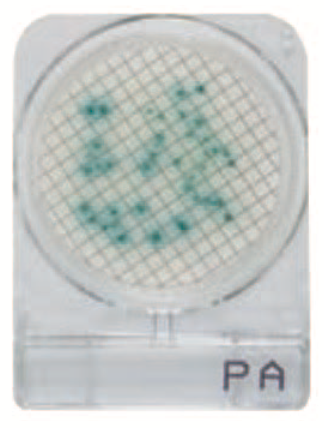
微生物快速测试片—铜绿假单胞菌
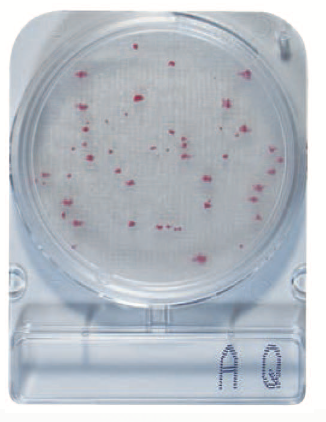
微生物快速测试片—水异养菌，CompactDry AQ
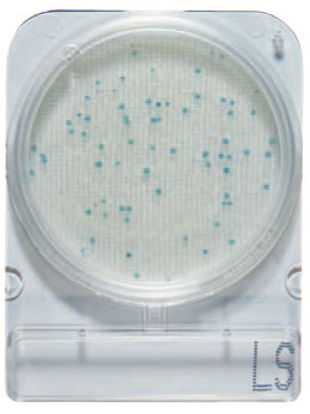
微生物快速测试片—李斯特氏菌属，CompactDry LS
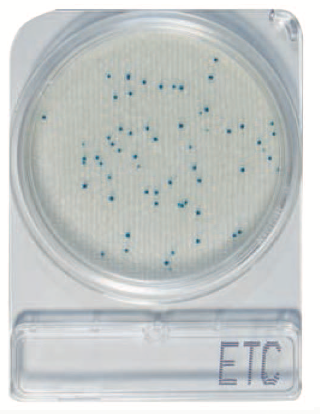
微生物快速测试片—肠球菌属，Compact Dry ETC

产品中心搜索
...
登录会员可看价格
...
登录会员可看价格
CompactDry 微生物快速测试片使用方法CompactDry 微生物快速测试片应用领域及特点CompactDry 微生物快速测试片采样方式CompactDry 微生物快速测试片大肠埃希氏菌CompactDry 微生物快速测试片自动计数...
登录会员可看价格
CompactDry 微生物快速测试片使用方法CompactDry 微生物快速测试片应用领域及特点CompactDry 微生物快速测试片采样方式CompactDry 微生物快速测试片铜绿假单胞菌CompactDry 微生物快速测试片自动计数...
登录会员可看价格
CompactDry 微生物快速测试片使用方法CompactDry 微生物快速测试片应用领域及特点CompactDry 微生物快速测试片采样方式CompactDry 微生物快速测试片水异养菌CompactDry 微生物快速测试片自动计数...
登录会员可看价格
CompactDry 微生物快速测试片使用方法CompactDry 微生物快速测试片应用领域及特点CompactDry 微生物快速测试片采样方式CompactDry 微生物快速测试片李斯特氏菌属CompactDry 微生物快速测试片自动计数...
登录会员可看价格
CompactDry 微生物快速测试片使用方法CompactDry 微生物快速测试片应用领域及特点CompactDry 微生物快速测试片采样方式CompactDry 微生物快速测试片肠球菌属CompactDry 微生物快速测试片自动计数...
登录会员可看价格
Compact Dry VP 辅助判读指南 岛津 Compact Dry 系列微生物测试片,采用类平皿设计,以无纺布形式承载培养基成分,其中副溶血弧菌测试片(Compact Dry VP )含有特异性酶底物,可以在20 小时快速检测副溶血弧菌,显蓝色/蓝绿色...
登录会员可看价格
Compact Dry YM· YMR辅助判读指南岛津 Compact Dry 系列微生物测试片,采用类平皿设计,以无纺布形式承载培养基成分,其中霉菌酵母测试片(Compact Dry YM· YMR )含有特异性酶底物,可以在快速同时检测霉菌酵母;其中酵母菌显蓝色或白色到淡黄色...
登录会员可看价格
CompactDry 微生物快速测试片使用方法CompactDry 微生物快速测试片应用领域及特点CompactDry 微生物快速测试片采样方式CompactDry 微生物快速测试片单核细胞增生李斯特氏菌CompactDry 微生物快速测试片自动计数...
登录会员可看价格